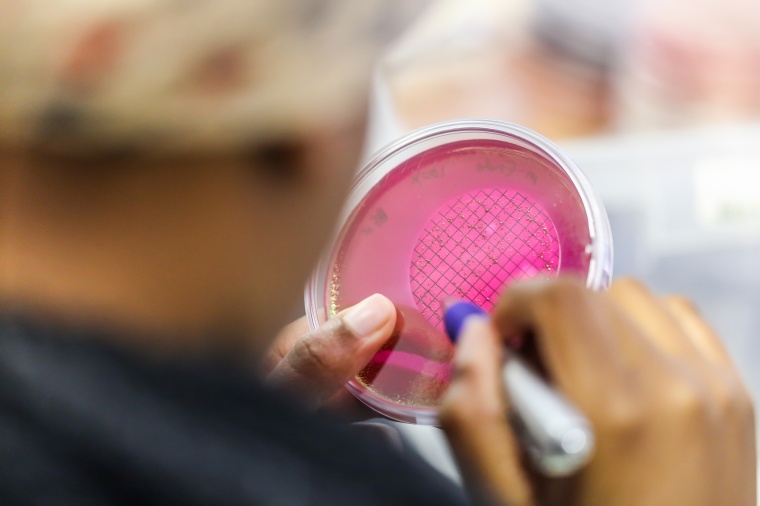
Persistente Bakterien verursachen wiederkehrende, schwierig behandelbare...

Wie sich Bakterien bei Antibiotikaangriffen schlafend stellen
Auch ohne Resistenz können Bakterien eine Antibiotikabehandlung überstehen.
Sie verlangsamen ihren Stoffwechsel und überleben so den Angriff „im Schlaf". Ein vom Schweizerischen Nationalfonds (SNF) gefördertes Forschungsteam fand heraus, was sich in den Bakterien verändert, wenn sie sich in den Zustand der Persistenz versetzen.
Resistente Bakterien entziehen sich der Wirkung von Antibiotika, indem sie unempfindlich werden, z.B. indem sie Antibiotika abbauen. Es gibt aber noch eine andere Überlebensstrategie für Bakterien: Sie versetzen sich in einen schlafähnlichen Zustand, um eine Behandlung mit Antibiotika auszuhalten – sie werden persistent. Nach Abschluss der Therapie erwachen sie zu neuem Leben und verursachen wiederkehrende, schwierig zu behandelnde Infektionen. Forschende haben nun mit Unterstützung des SNF neue Erkenntnisse zu dieser Bakterienpopulation gewonnen und könnten damit den Weg zu wirksamen Behandlungen ebnen. Die Ergebnisse sind in der Zeitschrift PNAS erschienen.
Das Forschungsteam arbeitete in dieser Studie mit dem Bakterium Staphylococcus aureus, das bei vielen Menschen auf der Haut vorkommt und häufig invasive und schwierig zu behandelnde Infektionen hervorruft. Von einem infizierten Patienten haben die Forschenden Bakterien entnommen und in Petrischalen kultiviert. Es zeigte sich, dass gewisse Bakterienkolonien kleiner waren als die anderen. „Daran erkennen wir, dass persistente Bakterien in der Probe sind", erklärt Annelies Zinkernagel, Professorin für Infektiologie an der Universität und dem Universitätsspital Zürich und eine der Autorinnen des Artikels. „Persistente Bakterien müssen im Gegensatz zu den übrigen Bakterien zuerst ‹erwachen›, was zu einer Wachstumsverzögerung im Nährmedium führt." Der Nachweis und die Analyse persistenter Bakterien in einer Patientenprobe sind insofern besonders interessant, da die meisten bisherigen Studien zu persistenten Bakterien im Labor mit über längere Zeit kultivierten Bakterien stattfanden und nicht mit solchen, die direkt aus dem Patienten stammen.
Protein-Atlas der persistenten Bakterien
Um herauszufinden, unter welchen Bedingungen die Bakterien persistent werden, führten die Forschenden verschiedene Stresstests durch. Stressfaktoren sind z.B. die Anwesenheit menschlicher Immunzellen, Antibiotika oder eine saure Umgebung, wie sie in Abszessen herrscht. Resultat: Je extremer die Bedingungen gestaltet wurden, desto höher wurde der Anteil dieser persistenten Bakterien.
Mit den Bakterien direkt aus dem Patienten analysierten die Forschenden zudem, wie die Persistenzmechanismen funktionieren. Dafür untersuchten sie alle bakteriellen Proteine, das Proteom. Es zeigte sich, dass eine umfassende molekulare Neuprogrammierung stattgefunden hatte, die eine Verlangsamung des Stoffwechsels bewirkte. Das Resultat war jedoch nicht ein vollkommener Stillstand, sondern eine Art Dämmerzustand. So steigern die Bakterien ihre Überlebenschancen in einer feindlichen Umgebung. Eine weitere Beobachtung: Sobald die Umgebung wieder freundlicher wird, machen die persistenten Bakterien diese Änderungen rückgängig und gewinnen damit ihre Infektionskraft zurück.
„Die Vorstellung, dass Bakterien ihren Metabolismus nicht anhalten, sondern lediglich verlangsamen und verändern, ist nicht ganz neu, aber noch umstritten", erklärt Zinkernagel. „Unsere Studie bestätigt dies mit hoher Präzision." Dies, weil sie hauptsächlich mit persistenten Bakterien gearbeitet habe. „Frühere Experimente beruhten auf gemischten Populationen, und das Ergebnis war deshalb möglicherweise durch die übrigen Bakterien, die für gewöhnlich in der Überzahl sind, verzerrt."
Neue Behandlungen am Horizont
Das bessere Verständnis dieser Mechanismen könnte zur Entwicklung neuer Behandlungen gegen persistente Bakterien beitragen. Die Forschenden zeigten zudem, dass Vitamin-A-Derivate, welche die Zellmembran ins Visier nehmen, ein vielversprechendes Potenzial für die Bekämpfung von Bakterien mit verlangsamtem Metabolismus aufweisen. Ein weiterer Ansatz: „Wenn es uns gelingt, das Wachstum dieser Bakterien zu reaktivieren, könnten sie sich den Antibiotika vermutlich nicht mehr entziehen", hofft die Forscherin.
Die Bekämpfung persistenter Bakterien ist zudem auch wichtig im Kampf gegen Resistenzen, da wiederkehrende Infektionen über einen längeren Zeitraum mit Antibiotika behandelt werden müssen. Durch diese ständige Exposition steigt das Risiko, dass sich Resistenzen entwickeln.














